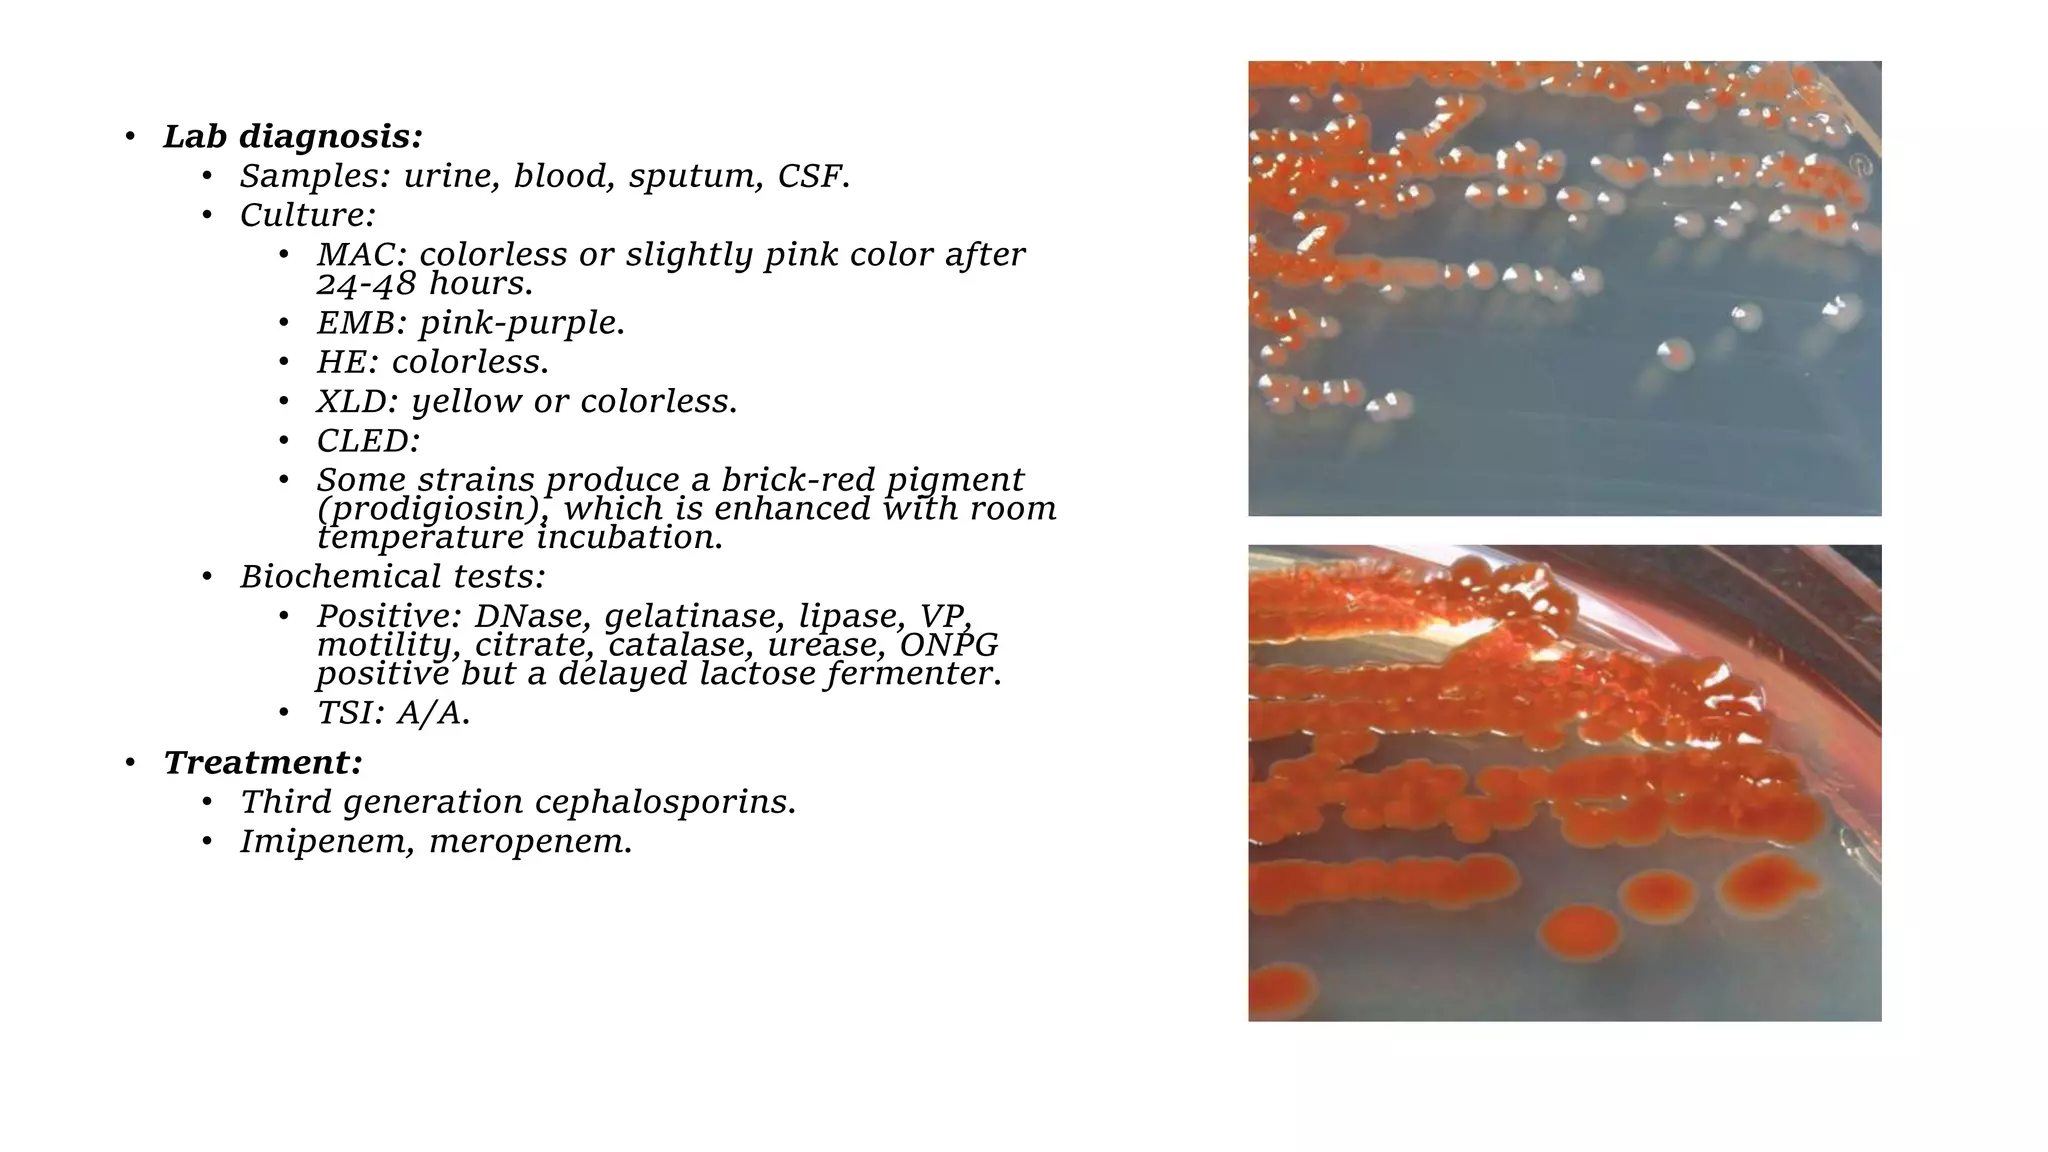
• Lab diagnosis:
• Samples: urine, blood, sputum, CSF.
• Culture:
• MAC: colorless or slightly pink color after
24-48 hours.
• EMB: pink-purple.
• HE: colorless.
• XLD: yellow or colorless.
• CLED:
• Some strains produce a brick-red pigment
(prodigiosin), which is enhanced with room
temperature incubation.
• Biochemical tests:
• Positive: DNase, gelatinase, lipase, VP,
motility, citrate, catalase, urease, ONPG
positive but a delayed lactose fermenter.
• TSI: A/A.
• Treatment:
• Third generation cephalosporins.
• Imipenem, meropenem.
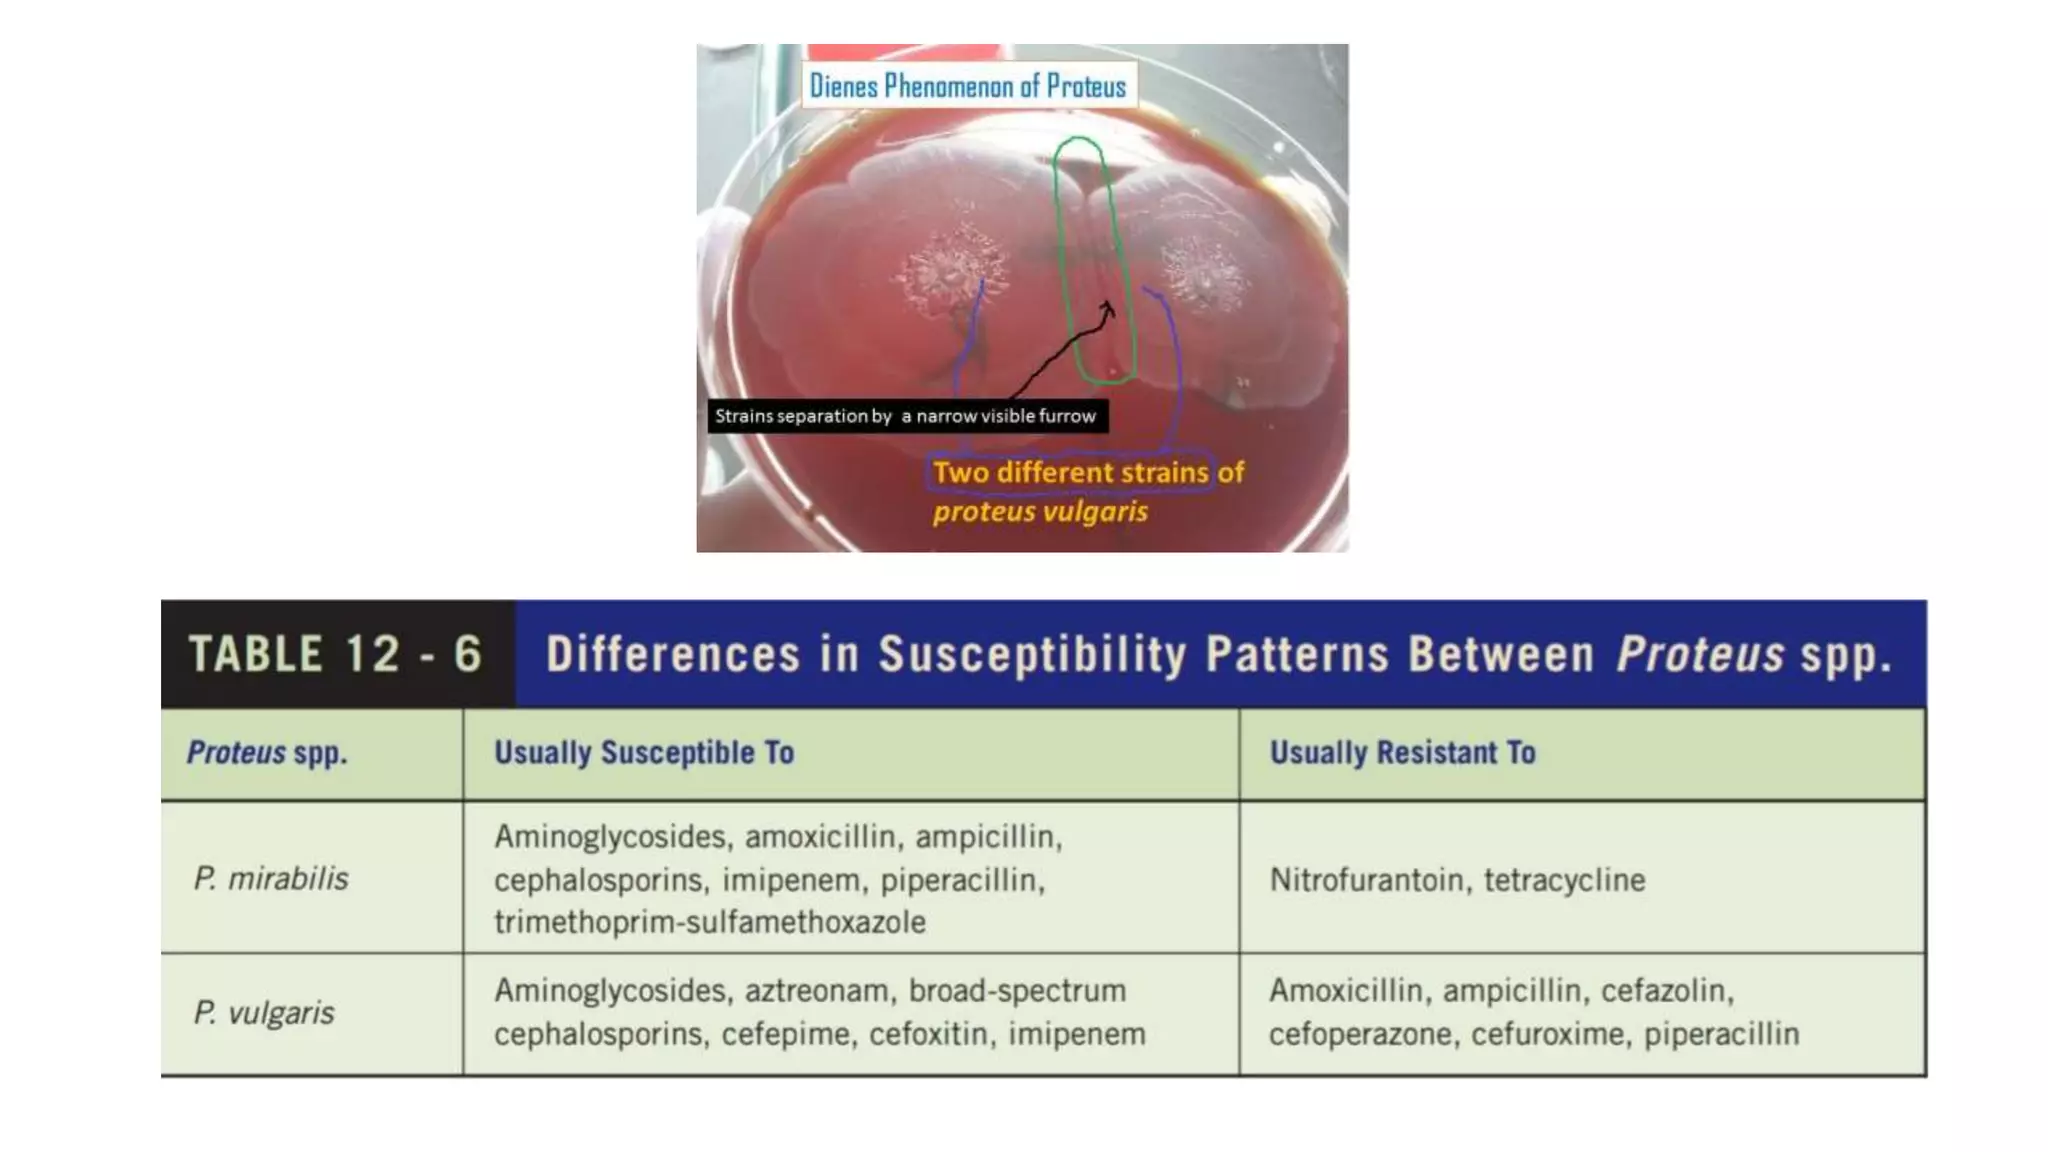

The document discusses the Enterobacteriaceae family, highlighting its medically important gram-negative bacilli such as E. coli, Klebsiella, and Salmonella. It details their general characteristics, virulence factors, modes of transmission, associated diseases, and lab diagnostics. Each genus is described with specific features like infections caused, laboratory identification, and treatment options.